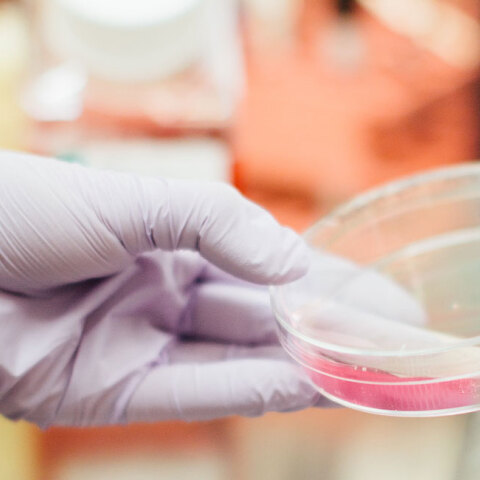
cell.jpg

Τα επιτύμβια αρχαϊκά αγάλματα στην Φθιώτιδα
- CITY GUIDE
- PODCAST
-
 17°
17°
ΑΝΑΚΑΛΥΨΕΙΣ
ΟΛΑ ΤΑ ΑΡΘΡΑ ΤΟΥ TAG
Ανακαλυψεις
Κοσμος
Κι όμως η Πομπηία δεν συνέβη την ημερομηνία που γνωρίζουμε (εικόνα, video)
Αλλά δύο μήνες αργότερα
Health & Fitness
Ο πρώτος μίνι τεχνητός ανθρώπινος οισοφάγος είναι γεγονός
Σπουδαίο ιατρικό επίτευγμα
Κοσμος
Επιστήμονες ισχυρίζονται ότι ανακάλυψαν την τοποθεσία, όπου έγινε ο Γάμος της Κανά (εικόνες)
Το πρώτο θαύμα του Ιησού
Κοσμος
Τεράστια ανακάλυψη: Στο φως μοναδικός κοραλλιογενής ύφαλος χιλιάδων ετών (εικόνα)
Για «βουνά από κοράλλια» έκαναν λόγο οι επιστήμονες
Κοσμος
Αδιάσειστες αποδείξεις - Νερό σε μορφή πάγου στη σκοτεινή πλευρά της Σελήνης (εικόνες)
Τι αποκαλύπτουν οι φωτογραφίες που τράβηξε η ινδική αποστολή Chandrayaan-1 πριν από 10 χρόνια
Ελλαδα
Ανακαλύφθηκε άθικτος Μινωικός τάφος στην Ιεράπετρα (εικόνες)
Ο αρχαιολογικός θησαυρός, ευτυχώς, δεν έχει συληθεί